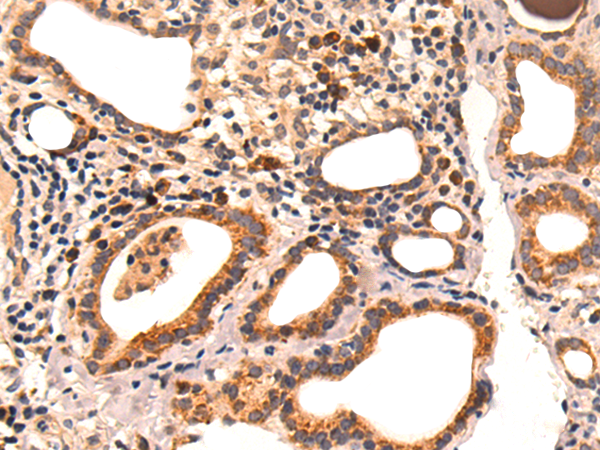

-
分类: 科研抗体货号: P10284别名: L18应用: IHC反应种属: Human, Mouse, Rat
-
分类: 科研抗体货号: P10265别名: CDA03; RS21C6; XTP3TPA应用: IHC反应种属: Human
-
分类: 科研抗体货号: P10283别名: MRPS35; HSPC007; MRP-S28; MRP-S35应用: WB,IHC反应种属: Human
-
分类: 科研抗体货号: P10264别名: ATP5D应用: IHC反应种属: Human, Mouse, Rat
-
分类: 科研抗体货号: P10282别名:应用: IHC反应种属: Human
-
分类: 科研抗体货号: P10262别名: YANK1应用: WB,IHC反应种属: Human, Mouse
-
分类: 科研抗体货号: P10280别名: NCE2应用: IHC反应种属: Human, Mouse, Rat
-
分类: 科研抗体货号: P10291别名: HSPC166; C11orf55; LINC00610应用: IHC反应种属: Human, Mouse
-
分类: 科研抗体货号: P10279别名: MAGP; MAGP1; MAGP-1应用: IHC反应种属: Human, Mouse
-
分类: 科研抗体货号: P10290别名: PDIA13; TXNDC10应用: IHC反应种属: Human, Mouse

鄂公网安备42018502007531号
鄂公网安备42018502007531号

